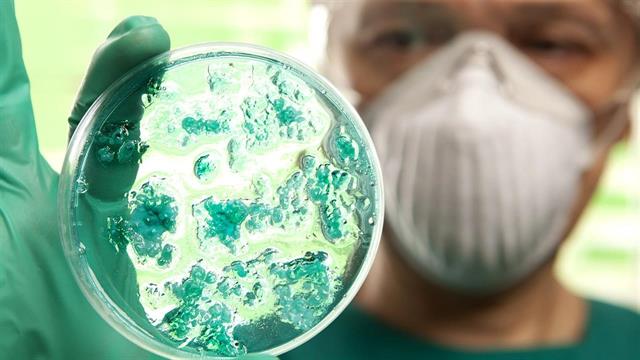
Έκθεση ΠΟΥ: 71% περισσότεροι θάνατοι από χολέρα παγκοσμίως

Πέρυσι, ο αριθμός των θανάτων από χολέρα αυξήθηκε δραματικά παγκοσμίως. Ο Παγκόσμιος Οργανισμός Υγείας (ΠΟΥ) ανέφερε ότι αναφέρθηκαν 71% περισσότερα θανατηφόρα κρούσματα σε σχέση με το 2022.
Ο αριθμός των δηλωθέντων κρουσμάτων αυξήθηκε κατά 13%. Περισσότεροι από 4.000 άνθρωποι πέθαναν πέρυσι από τη λοίμωξη που μπορεί να προληφθεί και να θεραπευτεί.
Αναφέρθηκαν συνολικά 535.321 κρούσματα, το 38% των οποίων αφορούσαν παιδιά κάτω των πέντε ετών.
Καθώς δεν καταγράφονται και δεν διαγιγνώσκονται παντού όλα τα κρούσματα, ο ΠΟΥ θεωρεί ότι ο πραγματικός αριθμός είναι σημαντικά υψηλότερος. Η χολέρα είναι μια διαρροϊκή ασθένεια κατά την οποία ο οργανισμός χάνει πολλά υγρά. Αυτό μπορεί να οδηγήσει σε νεφρική ανεπάρκεια και θάνατο.
Οι άνθρωποι συνήθως μολύνονται μέσω της κατανάλωσης νερού μολυσμένου με περιττώματα ή εμετό από άρρωστους ανθρώπους ή μέσω της κατανάλωσης μολυσμένων τροφίμων.
Στην Αφρική, ο αριθμός των κρουσμάτων έχει υπερδιπλασιαστεί, ενώ στην Ασία και τη Μέση Ανατολή έχει μειωθεί κατά περίπου ένα τρίτο.
Σύμφωνα με τις προκαταρκτικές εκθέσεις, ο αριθμός των κρουσμάτων παρέμεινε υψηλός και φέτος: Μέχρι στιγμής έχουν αναφερθεί στον ΠΟΥ 342.000 κρούσματα ασθένειας και 2.400 θάνατοι.
"Οι συγκρούσεις, η κλιματική αλλαγή, η ανεπαρκής παροχή νερού και η ανεπαρκής αποχέτευση, η φτώχεια, η υπανάπτυξη και ο εκτοπισμός πληθυσμών λόγω νέων και αναζωπυρούμενων συγκρούσεων και φυσικών καταστροφών συνέβαλαν στην αύξηση των κρουσμάτων χολέρας κατά το περασμένο έτος", δήλωσε ο Οργανισμός.
Σύμφωνα με τον ΠΟΥ, υπάρχουν πάρα πολύ λίγα διαθέσιμα εμβόλια. Πέρυσι, παρήχθησαν 36 εκατομμύρια δόσεις εμβολίου, αλλά οι χώρες χρειάζονταν στην πραγματικότητα διπλάσια ποσότητα. Η παραγωγή ενισχύεται με κάθε δυνατό μέσο.
Προσθέστε το iatronet.gr στο DiscoverΕιδήσεις υγείας σήμερα
Συντηρητικά τροφίμων: Αναγκαία "ασπίδα", αλλά και κρυφοί κίνδυνοι
Κάπνισμα: Η άσκηση βοηθά στη διακοπή του
Απάτη 400.000 σε βάρος του ΕΟΠΥΥ - Εγκέφαλος της οργάνωσης πρώην υποψήφιος βουλευτής
Επιδημία χολέρας στη βορειοανατολική Νιγηρία
Επιδημία χολέρας στη βορειοανατολική Νιγηρία Διατροφή υψηλή σε πρωτεΐνη θα μπορούσε να μειώνει σημαντικά τις λοιμώξεις από χολέρα [μελέτη]
Διατροφή υψηλή σε πρωτεΐνη θα μπορούσε να μειώνει σημαντικά τις λοιμώξεις από χολέρα [μελέτη] ΠΟΥ: Εξάπλωση της χολέρας - Οι συγκρούσεις την τροφοδοτούν
ΠΟΥ: Εξάπλωση της χολέρας - Οι συγκρούσεις την τροφοδοτούν Επιδημία χολέρας σε 23 αφρικανικές χώρες
Επιδημία χολέρας σε 23 αφρικανικές χώρες ECDC: Και δεύτερο ύποπτο κρούσμα χολέρας στην Πολωνία
ECDC: Και δεύτερο ύποπτο κρούσμα χολέρας στην Πολωνία Πάνω από 1.600 νεκροί από χολέρα στο Σουδάν
Πάνω από 1.600 νεκροί από χολέρα στο Σουδάν Συντηρητικά τροφίμων: Αναγκαία "ασπίδα", αλλά και κρυφοί κίνδυνοι
Συντηρητικά τροφίμων: Αναγκαία "ασπίδα", αλλά και κρυφοί κίνδυνοι Συνήθειες των αιωνόβιων που καλό είναι να ακολουθούμε
Συνήθειες των αιωνόβιων που καλό είναι να ακολουθούμε Συμπληρώματα διατροφής και πικρή γεύση στο στόμα: Τι να κάνω
Συμπληρώματα διατροφής και πικρή γεύση στο στόμα: Τι να κάνω Εντοπίστηκε σχέση μεταξύ περιοδοντίτιδας και νεφρικής νόσου
Εντοπίστηκε σχέση μεταξύ περιοδοντίτιδας και νεφρικής νόσου Στατίνες: Προκαλούν σοβαρά μυϊκά προβλήματα;
Στατίνες: Προκαλούν σοβαρά μυϊκά προβλήματα; Pfizer: Νέα ιατρική διευθύντρια η Χριστίνα Μιχαηλίδη
Pfizer: Νέα ιατρική διευθύντρια η Χριστίνα Μιχαηλίδη Ιδέες για πρωινό με πολλή πρωτεΐνη
Ιδέες για πρωινό με πολλή πρωτεΐνη Aνατροπή της τελευταίας στιγμής
Aνατροπή της τελευταίας στιγμής Ανακαλείται επιδόρπιο γάλακτος πουτίγκας με γεύση σοκολάτα
Ανακαλείται επιδόρπιο γάλακτος πουτίγκας με γεύση σοκολάτα Τι ζητούν οι Τεχνολόγοι Ιατρικών Εργαστηρίων
Τι ζητούν οι Τεχνολόγοι Ιατρικών Εργαστηρίων Pharmathen: Αναδιάρθρωση χρέους έως 664,5 εκατ. ευρώ, που θωρακίζει τους δανειστές
Pharmathen: Αναδιάρθρωση χρέους έως 664,5 εκατ. ευρώ, που θωρακίζει τους δανειστές Τι πιστεύουν οι υγειονομικοί για τον αντιγριπικό εμβολιασμό [έρευνα]
Τι πιστεύουν οι υγειονομικοί για τον αντιγριπικό εμβολιασμό [έρευνα]